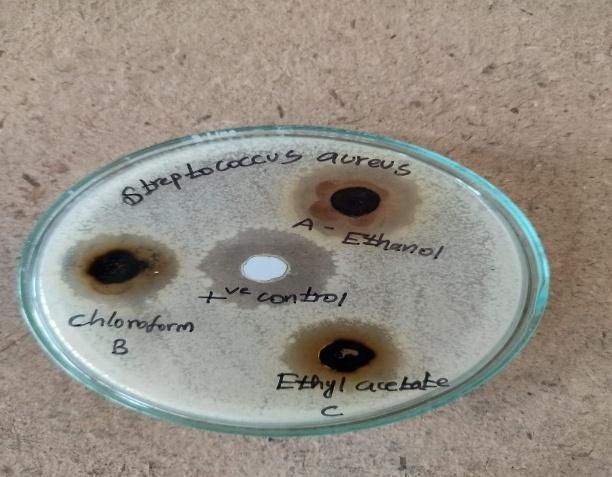
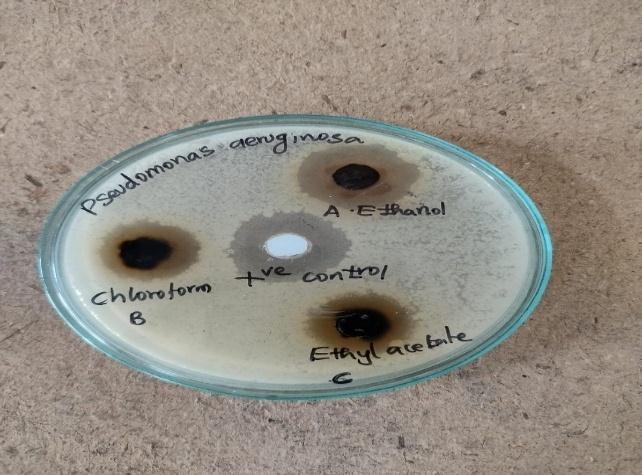

International Research Journal of Engineering and Technology (IRJET) e-ISSN: 2395-0056
Volume: 12 Issue: 12 | Dec 2025 www.irjet.net p-ISSN: 2395-0072
PRELIMINARY PHYTOCHEMICAL SCREENING AND ANTIMICROBIAL ACTIVITY (STAPHYLOCOCCUS AUREUS AND PSEUDOMONAS AERUGINOSA) OF THESPESIA POPULNEA LEAF EXTRACTS BY DIFFERENT SOLVENTS
Dr. K.L. Senthilkumar1 , G. Deepan Chakravarthi2, S. Dhanalakshmi3 , M. Dhanush Kumar4
1 , Principal, Sri Vijay Vidyalaya College of Pharmacy, Dharmapuri, Tamil Nadu (India) 2, 3, 4, B. Pharm, Students, Sri Vijay Vidyalaya College of Pharmacy, Dharmapuri, Tamil Nadu (India) ***
Abstract: The objective of the study is preliminary phytochemical screening and antimicrobial activity. The Thespesia populnea extract was made by using different solvents.
Method: The collected leaves were shade-dried and ground into a coarse powder. The powdered plant material was subjected to successive extraction using ethanol, chloroform, and ethyl acetate. The extracts were then analyzed for preliminary phytochemical constituents and tested for antimicrobial activity.
Conclusion: Thespesia populnea leaves have antibacterial activity against pathogenic microorganisms like Staphylococcus aureus and Pseudomonas aeruginosa. The given ethanol extract shows good antibacterial activity when compared to the chloroform and ethyl acetate
Key words: Thespesia populnea(L), Soxhlet method, phytochemical screening, anti-microbial activity.
I. INTRODUCTION
Thespesia populnea (L.) Soland. Ex.Correa, commonly referred to as the ‘Portia tree’ or ‘Indian tulip tree,’ belongs to the familyMalvaceae.Itisasmall-tomedium-sizedtreetypicallyfoundalongcoastalregions.Thetreeattainsaconsiderable heightduringits15-metregrowth[1].
Thestembark,leaves,flowers,andfruitshavebeentraditionallyusedinthetreatmentofcutaneousinfections,including scabies,psoriasis,eczema,ringworm,andguineaworm[2].
The plant was found to be rich in diverse phytochemicals such as alkaloids and glycosides, flavonoids, terpenoids, carbohydrates,proteins,steroids,andcolouringagents.[3].
The present study was designed to determine the antimicrobial activity of ethanol, chloroform, and ethyl acetate leaf extract of Thespesia populnea to estimate MHA of the selected extract against Streptococcus aureus and Pseudomonas aeruginosaandtocompareitsantimicrobialactivitywiththewell-knownantibioticchloramphenicol[4].


International Research Journal of Engineering and Technology (IRJET) e-ISSN: 2395-0056
Taxonomical classification:
Taxonomy: Thespesiapopulnea
Kingdom:Plantae
Division: Magnoliophyta
Class: Magnoliopsida
Subclass: Magnoliidae
Order: Malvales
Family: Malvaceae
Genus: Thespesia
Species: Populnea
Vernacular Name:
English: Indiantuliptree,portiatree,corktree,umbrellatree.
Tamil: puvarasam,puvaraassu,poris,kallal,karvarachu.
Hindi: parasapeepala
Telugu: Gangararichettu
II. MATERIALS AND METHODS
Leaves and materials:
The Thespesia populnea leavesusedinthestudy arecollectedfrom theCollectorate, Dharmapuri.Thecollectedsamples were carefully cleaned and rinsed two to three times with distilled water. The leaves were then shade-dried under ambientconditionsforsevendays.Theirdeadleavesarecoarselygroundandmakecoarsetalc.
Materials:
Soxhletextractor
Extractionthimble
Solvents[ethanol,chloroform,ethylacetate]
Sample[coarsepowder]
Heatingmantle
Condenser
Preparation of extracts:
ThepreparationofextractsfromthepowderedleavesofThespesiapopulneaisdonebyusingthefollowingsolvent:
1. Ethanolextract
2. Chloroformextract
3. Ethylacetateextract
Ethanol extract
The shade-dried coarse powder of fifty grams of leaves was packed well in a Soxhlet apparatus and subjected to continuous hot extraction with 500 ml of ethanol for 18 hours. The extract was distilled in a vacuum under pressure in order to remove the solvent completely. The extract was dried and kept in a desiccator until use. The dried extract was thenweighed,andthepercentageyieldwasdeterminedbasedontheair-driedcrudedrug.
Volume: 12 Issue: 12 | Dec 2025 www.irjet.net p-ISSN: 2395-0072 © 2025, IRJET | Impact Factor value: 8.315 | ISO 9001:2008 Certified Journal | Page982

International Research Journal of Engineering and Technology (IRJET) e-ISSN: 2395-0056
Volume: 12 Issue: 12 | Dec 2025 www.irjet.net p-ISSN: 2395-0072
Chloroform extract:
Fifty grams of shade-dried leaf powder were coarsely ground and packed into a Soxhlet apparatus for continuous hot extractionusing500mlofchloroformfor18 hrs.Theobtainedextractwasconcentratedusingvacuumdistillationunder reduced pressure to remove the solvent completely. The dried extract was subsequently stored in a desiccator until further use. The extract was weighed, and the percentage yield was calculated with respect to the air-dried powdered crudedrug.
Ethyl acetate extract:
Fifty grams of shade-dried coarsely powdered leaves were tightly packed into a Soxhlet apparatus and extracted continuously with 500 ml of ethyl acetate for 18 hrs under hot conditions. The resulting extract was concentrated by vacuumdistillationunderreducedpressuretocompletelyremovethe solvent.The driedextractwaskeptinadesiccator untilfurtheruse.Theextractwasthenweighed,andthepercentageyieldwascalculatedrelativetotheair-driedpowdered crudedrug.
III. PHYTOCHEMICAL ANALYSIS OF THESPESIA POPULNEA
Test for alkaloids:
Dragendorff’s test:
OnemLoftheextractwasmixedwith1mLofDragendorff’sreagent(potassiumbismuthiodidesolution).Theformation ofanorangeprecipitateindicatedthepresenceofalkaloids.
Test for glycosides:
Test sol: Itwaspreparedbydissolvingthesampleinalcohol.
Killer Killiani test:
Totestthesolution,afewdropsofferricchloridesolutionwereaddedtoconcentratedsulphuricacid.Thisresultedinthe formulationoftwodistinctlayersareddish-brownlowerlayerandabluish-greenupperlayer.
Test for carbohydrates:
Mulish test:
To 2-3 ml of the test solution, a few drops of Molisch reagent were added, and the mixture was shaken. Concentrated sulfuric acid was then carefully added along the side of the test tube, resulting in the formation of a violet ring at the junctionofthetwoliquids.
Test for terpenoids:
1mlofextractwastakeninatesttube,and2mlofchloroformwasaddedtoit,followedbytheadditionof3mlofcon. The formation of a reddish-brown layer at the interface of the two solutions upon the addition of sulfuric acid confirms the presenceofterpenoids.
Test for Flavonoids:
A small quantity of the extract was treated with lead acetate, resulting in the formation of a yellow precipitate, which indicatesthepresenceofflavonoids.
Test for Tannins:
Test solution: thetestsolutionwaspreparedbydissolvingtheextractinamixtureofwaterandalcohol.
Ferric chloride solution test:
To1mloftheextract,ferricchloridewasadded,resultingintheformationofadarkblueorgreenish-blackcoloration.

International Research Journal of Engineering and Technology (IRJET) e-ISSN: 2395-0056
Volume: 12 Issue: 12 | Dec 2025 www.irjet.net p-ISSN: 2395-0072
Test for Saponins:
Test solution: Thesolutionwaspreparedbydissolvingtheextractinwatertoobtainanaqueoussolution.
Foam test:
Thedryextractwasvigorouslyshakenwithwater.Theabsenceofpersistentfoamindicatestheabsenceofsaponins.
Test for proteins:
Test sol: Theextractwasdissolvedinwatertoobtainanaqueousextract.
Biuret test:
To 2-3 ml of the extract solution, sodium hydroxide and a few drops of copper solution were added, resulting in the formationofabluecolor.
Test for Fat:
Solubility test:Fatsareinsolubleinwaterandethanolbutsolubleinchloroform,benzene,andetherinthepresenceoffat.
Test for cholesterol:
Add2mlofchloroformwith10dropsofaceticanhydrideandadd2-3dropsofconc.sulphuricacid,whichappearsroseredincolorandshowstheabsenceofcholesterol.
Test for steroids:
Add extract solution, a few drops of chloroform, and a few drops of conc. sulphuric acid; it gives a reddish-brown ring interface.
TABLE 01: Phytoconstituentsofethanol,chloroform,andethylacetateofdriedleavesofThespesiapopulnea(L).
IV. ANTIMICROBIAL ACTIVITY OF THESPESIA POPULNEA
Test microorganisms:
Atotalofonebacterialstrainwasusedthroughouttheinvestigation.BacterialcultureswereobtainedfromtheMicrobial Type Culture Collection, the Institute for Microbial Technology, and Chandigarh, India. The bacteria used were StaphylococcusaureusandPseudomonasaeruginosa.

International Research Journal of Engineering and Technology (IRJET) e-ISSN: 2395-0056
Volume: 12 Issue: 12 | Dec 2025 www.irjet.net p-ISSN: 2395-0072
ANTI-BACTERIAL ASSAY:
1. Preparation of inoculum:
Stock cultures were maintained at 4°C on slopes of nutrient agar. Active bacterial cultures were prepared by transferringaloopfullofcellsfromthestockculturesintoatesttubecontainingMuller-Hintonbroth(MHB).The culturewasincubatedat37°Cfor24hours.ThebacterialculturesweredilutedusingfreshMuller-Hintonbrothto obtainadensityequivalentto2.0X106colony-formingunits(CFU/ml)forbacteria(Smith&Doe2018).
2. Preparation of sterile swabs:
Cotton wool swabsmadeon wood or plasticshaftswerepreparedand sterilized either byautoclaving or by dry heat(thelattermethodwasusedonlyforthewoodenswabs).Sterilizationwascarriedoutbypackingtheswabs intoculturetubes,wrappingtheminpaper,andplacingthemintins,asappropriate.
3. Sterilization of forceps:
Sterilizationofforcepscanbeachievedbydippingtheminalcoholfollowedbyflamingtoremovethealcohol.
Antibacterial assay using the agar well diffusion method:
Theantibacterialactivityofcrudedrugextractswasdeterminedbythewelldiffusionmethod.
In this study, the antibacterial activity of the test sample was assessed using Mueller-Hinton agar (MHA), a standard nutrientmediumrecommendedforantimicrobialsusceptibilitytesting.Muller-Hintonagar(MHA)obtainedfromHimedia (Mumbai) was prepared by pouring approximately 50 mL of molten medium into sterile petri dishes and allowing it to solidify.
A0.1%bacterialinoculumwaspreparedanduniformlyspreadovertheagarsurfaceusingasterilecottonswabtoensure evenmicrobialgrowth.Theplatewaskeptasideforafewminutestoallowtheinoculumtodry.
Sterilewellsofequaldiameterweremadeontheagarusingacorkborer,and100µlofthetestextractwascarefullyadded toeachwell.Astandardantibiotic,chloramphenicol,wasusedasthepositivecontroltocomparetheactivityofthesample diffused into the medium and acting against the bacteria. After incubation, antibacterial activity was evaluated by measuringthezoneofinhibition.
Theantimicrobialactivitywasassessedusingtheagarwelldiffusionmethod.Theextractexhibitedantibacterialactivities againstthetestedmicroorganism.
Table 02: Antibacterial activity of ethanol, chloroform and ethyl acetate with 100 µl concentration

International Research Journal of Engineering and Technology (IRJET) e-ISSN: 2395-0056
Volume: 12 Issue: 12 | Dec 2025 www.irjet.net p-ISSN: 2395-0072
ANTI MICROBIAL ACTIVITY Streptococcu s aureus
Pseudomonas aeruginosa

International Research Journal of Engineering and Technology (IRJET) e-ISSN: 2395-0056
Volume: 12 Issue: 12 | Dec 2025 www.irjet.net p-ISSN: 2395-0072
V.CONCLUSION
The given sample shows the antibacterial activity against pathogenic microorganisms, such as Staphylococcus aureus (20 mm) and Pseudomonas aeruginosa (21 mm). The ethanol extract demonstrated significant antimicrobial activity against both Staphylococcus aureus and Pseudomonas aeruginosa compared to the chloroform and ethyl acetate extract. Among the extracts tested, the ethanol extract showed the highest efficacy, while the ethyl acetate extract. Extract exhibitedtheleastantimicrobialactivity.
REFERENCE
[1] Pratap Chandran, R., Manju, S., Vysakhi, M.V., Shaji P.K., Achuthan Nair, G. Antibacterial and antifungal effects of Thespesiapopulnealeafextractsagainsthumanpathogens,2014.
[2] R. Parthasararathy, R. Ilavarasan, C.M. Karunakaran, antidiabetic activity of Thespesia populnea bark and leaf extract againstStreptozotocin-induceddiabeticrats,
[3] Ushanandhini. S, Radhika. V, Manisha. S, Anusha Jeslin. V Phytochemical studies and antimicrobial compounds from fruitofThespesiaPopulnea(L)SolandExCorrea,2017
[4] Subodhani, S. Kumari, Nayani P, Attanayake and Bhagya Priyasri Antimicrobial activity of Thespesia populnea (L.) extractsagainstclinicalisolatesofmethicillin-resistantStaphylococcusaureus(MRSA),2023
[5]Kannan,C.S.,andWarrier,MuthupandiyanS.Thespesiapopulnea,amultipurposetreespecies,2023
[6] Smith, J. A., & Doe, R. B. (2018). Evaluation of the antimicrobial activity of herbal extracts against clinical pathogens. JournalofMicrobialResearch,12(3),234-240.
[7] National Committee for Clinical Laboratory Standards (NCCLS). (1993). Methods for dilution antimicrobial susceptibilitytestsforbacteriathatgrowaerobically(3rded.).NCCLS.
[8] T.Pavithra,T.Vinciya,P.Subathiradevi,DrS.SyedHussainPeeran,R.SnehaSriPhytochemicalscreeningofThespesia populneaethanolicextractsandestimationofitsantioxidantandantihelminticactivities,2024
[9] D. Sai Koteswar Sarma, A. Venkata Suresh Babu. Pharmacognostic and Phytochemical Studies of Thespesia Populnea Linn.,2011